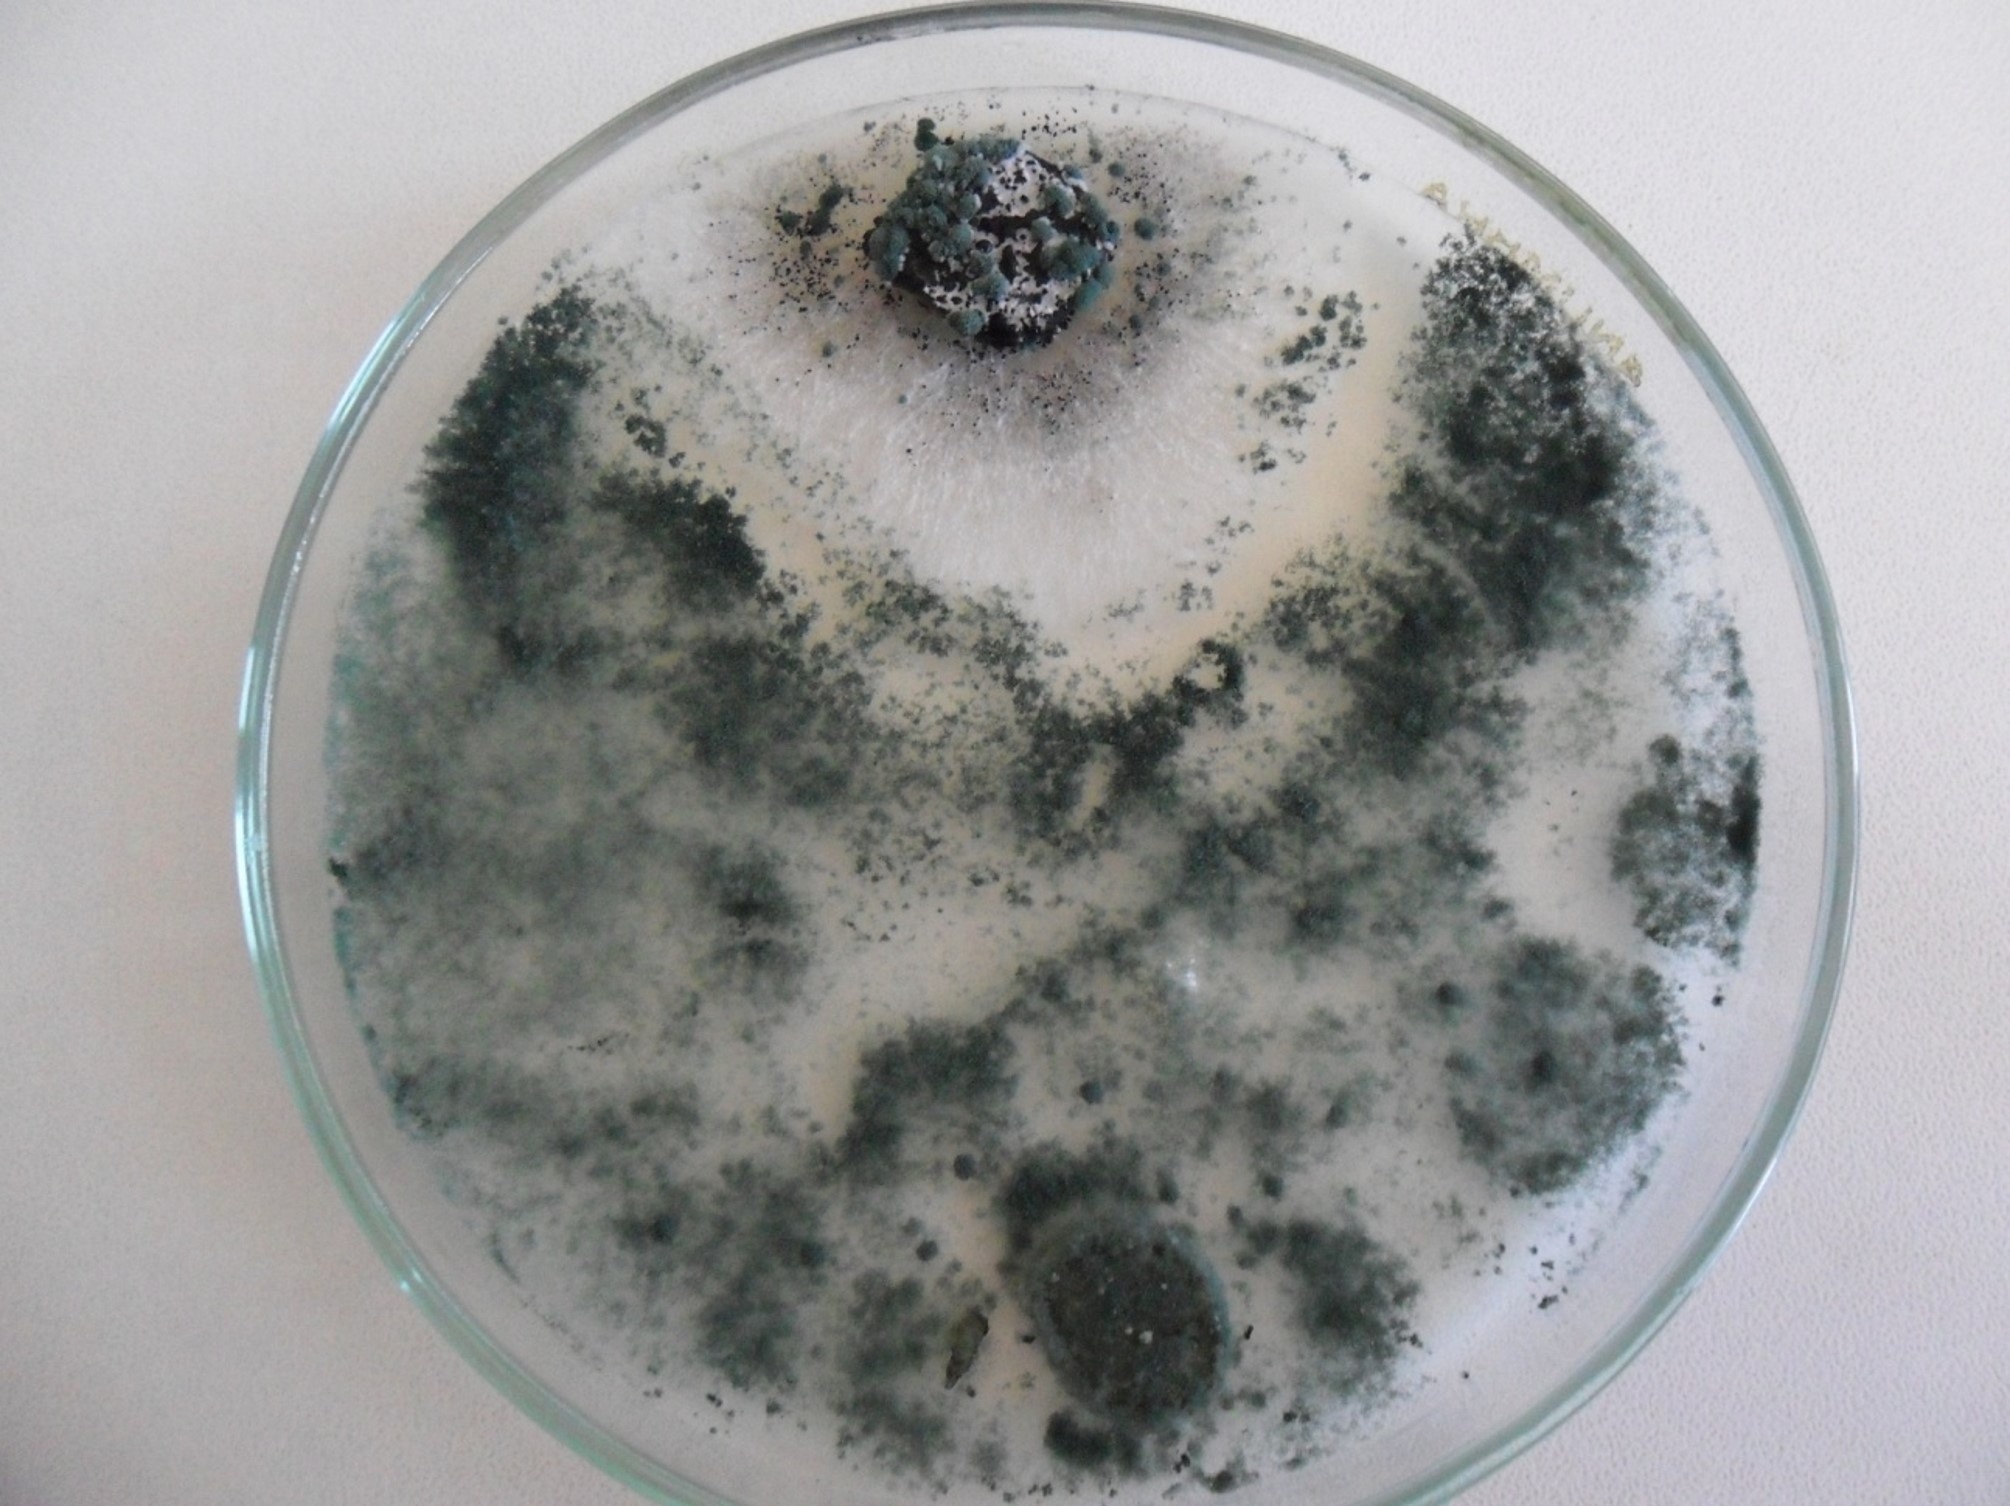

Trichoderma: o protagonista dos bioinsumos
Conheça o fungo eficiente no controle biológico e na promoção de crescimento vegetal
Trichoderma é o gênero fúngico de maior importância dentre os organismos utilizados no controle biológico. As pesquisas agrícolas com o gênero iniciaram da década de 1930. No Brasil, iniciaram na década de 1970 e sua aplicação começou a ganhar importância após os anos 2000. O primeiro registro de um produto à base de Trichoderma foi apenas em 2006.
De lá pra cá, o uso de biológicos ganhou força na agricultura brasileira, sendo uma técnica amplamente utilizada em diversas culturas. Na safra 21/22, 39% da área plantada no Brasil utilizou o controle biológico na estratégia de manejo de doenças e pragas. Em uma área de 19,1 milhões de ha, 98% foram com produtos microbiológicos, frente a 2% de macrobiológicos (Croplife Brasil, 2022).
O gênero Trichoderma é um dos mais utilizados em formulações de biológicos simples e compostos (com mais de um agente). Atualmente, 83 produtos estão registrados para controle biológico com Trichoderma na composição, sendo 9 nematicidas microbiológicos e 74 Fungicidas microbiológicos. Já na utilização como promotores de crescimento, há 7 produtos para soja e 3 para alface (dados coletados em junho de 2024 no aplicativo Bio Insumos do MAPA).
Mecanismos de ação
O que torna o Trichoderma tão especial, é o seu oportunismo: coloniza plantas, substratos de diferentes características e se adapta a diferentes ambientes, como em temperaturas extremas, solos salinos, ácidos, alcalinos e em condições de baixa disponibilidade hídrica. Por esse motivo, o gênero ganhou posição de destaque na agricultura brasileira, que é tão diversa em termos de clima e solo. Abaixo estão descritos os principais mecanismos de ação:
Micoparasitismo – A capacidade de parasitar outros fungos é uma das características mais relevantes de Trichoderma. Em Rhizoctonia solani (fungo causador de tombamento de podridão radicular em diversas culturas de interesse agrícola), é capaz de enrolar, penetrar e destruir o conteúdo das células. É classificado como micotrófico, já que se alimenta de outros fungos vivos e também a biomassa de fungos mortos. Produzem enzimas que degradam as paredes celulares, como as quitinases e glucanases. Essas enzimas produzidas por Trichoderma são as responsáveis pelo controle de inúmeros patógenos de plantas, como: Armillaria, Botrytis, Colletotrichum, Diaporthe, Fusarium, Helminthosporium, Macrophomina, Monilia, Monilinia, Nectria, Phoma, Phytophthora, Plasmopara, Pseudoperonospora, Pythium, Rhizoctonia, Rhizopus, Sclerotinia, Sclerotium, Ustilago, Venturia, Verticillium, etc. Além dessas, alguns gêneros produzem também proteases, que são capazes de agir no biocontrole de nematoides.
Figura 1: Pareamento entre Trichoderma sp. (abaixo) e Pestalotiopsis sp. (acima), patógeno de nogueira-pecã. É possível observar que Trichoderma sp. colonizou toda a placa, inclusive o patógeno
Antibiose – O gênero é um grande produtor de metabólitos secundários, sendo uma das maiores fontes do Reino Fungi. Muitos estudos em laboratório confirmam a atividade antifúngica desses metabólitos, mas dados em condições de campo ainda são escassos. Há também o relato da capacidade de controle de insetos-praga.

Figura 2: Pareamento entre Trichoderma sp. (abaixo) e Pestalotiopsis sp. (acima), patógeno de nogueira-pecã. Meio de cultura com a coloração amarelada em função da produção de metabólitos secundários por Trichoderma sp.
Competição – O Trichoderma é um excelente competidor, tanto por espaço quanto por recursos. Essa capacidade de competição o coloca na frente em relação a outros organismos, já que conseguem colonizar rapidamente o ambiente rizosférico. Apesar de ser um mecanismo chave, é necessário que a cepa apresente parasitismo e/ou antibiose, garantindo assim um controle biológico efetivo.

Figura 3: Pareamento entre Trichoderma sp. (abaixo) e Pestalotiopsis sp. (acima), patógeno de nogueira-pecã. Trichoderma sp. demonstrando a sua agressividade ao colonizar o patógeno.
Mecanismos de promoção de crescimento – o gênero é conhecido por produzir auxinas e metabólitos que auxiliam no desenvolvimento radicular. Plantas com um melhor desenvolvimento radicular tem acesso a mais recursos como água e nutrientes. Também incrementam a absorção e solubilização de nutrientes por processos como acidificação do meio, quelação, hidrólise e redox. Harman (2000) relatou que Trichoderma harzianum favoreceu a absorção de Nitrogênio em testes de campo com plantas milho.
Alívio de estresse salino – Alguns metabólitos produzidos por Trichoderma apresentam influência osmótica na planta, sendo capaz de reduzir a condutividade elétrica na região rizosférica, melhorando assim o desenvolvimento em condições de salinidade. Além disso, produzem substâncias anti-oxidantes, que reduzem danos causados por espécies reativas de oxigênio produzidas em condições estressantes como ambientes salinos.
Franquiéle Bonilha da Silva
Dra. em Ciência do Solo
Consultora Agronômica em PDI
Fontes:
CROPLIFE BRASIL. Sumário Executivo Biodefensivos: Mercado Brasileiro Safra 2021/22. 2022.
HARMAN, G. E. Myths and dogmas of biocontrol: changes in perceptions derived from research on Trichoderma harzianum T-22. Plant Disease, v. 84, 2000.
MEYER, M. C. et al. Trichoderma: uso na agricultura. Brasília, DF: Embrapa, 2019. 538p.
WEI, Y. et al. Trichoderma harzianum inoculation promotes sweet sorghum growth in the saline soil by modulating rhizosphere available nutrients and bacterial community. Frontiers in Plant Science, v. 14, 2023.
YASMEEN, R; SIDDIQUI, Z. S. Physiological responses of crop plants against Trichoderma harzianum in saline environment. Acta Botanica Croatica, v. 76, n. 2, 2017.